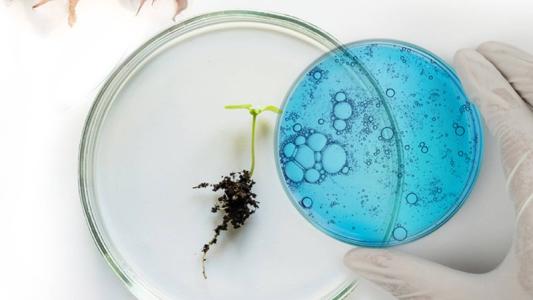

Contributor
Kristin Houser
Managing Editor
Contact
Kristin Houser is the Managing Editor of Freethink. Her articles on science and technology have been featured in NBC News, RealClearDefense, and the World Economic Forum’s Agenda, among other publications, and Stephen Colbert once talked about a piece on “The Late Show,” to her delight.
Kristin is currently based in Pittsburgh, and prior to joining Freethink, she was a staff writer for Futurism, launched an LA-based music blog, and wrote several animated and live action web series.